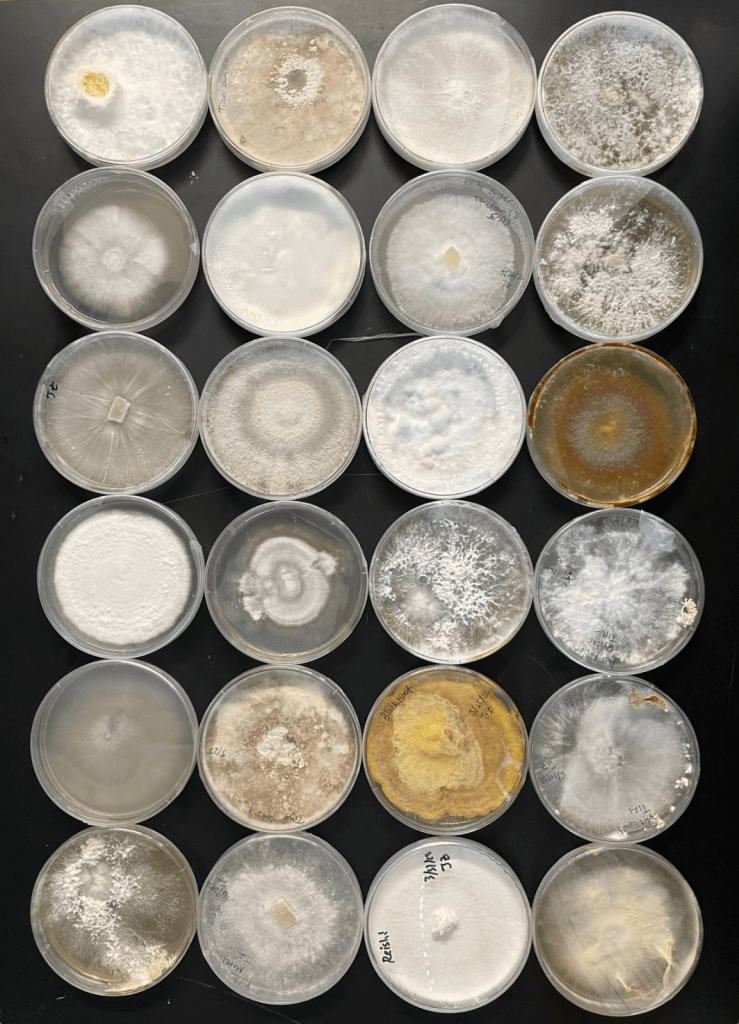

Knowledge, happiness, and wish for some use to the planet

Greetings!
I am a Boston-based scientist working at the interface of synthetic biology, microbial ecology and bioinformatics in Daniel Segrè‘s lab. I study the microbial communities that live on plant roots in a synthetic, laboratory environment. Using a combination of experimental and computational methods, I seek to understand how microbial interactions, based on resource competition and exchange, affect the assembly of different species into communities at different complexity.
Besides studying nature, I also developed synthetic biology tools to manipulate and engineer living systems, from acetogens that fix atmospheric CO2 in a microbial fuel cell, microbes that fix nitrogen for cereal plants, to mushroom-forming fungi that can be harnessed as alternative proteins or biomaterials.
Apart from research, I founded and led Elefam, China’s first animal welfare and nature conservation think-tank since 2016. Over the years, I mentored 70+ fellows who came from diverse disciplines to voice for the health of our planet. Through a wide range of media collaborations, government and philanthropy-funded projects, and interdisciplinary training programs, we reached an audience of millions, and influenced hundreds to thousands of young people to choose a career in conservation.
Right now I am bridging my passion in solving climate issues and my scientific training in synthetic biology to tap into the wonder of underexplored organisms to advance biomanufacturing.
Nature through my lens